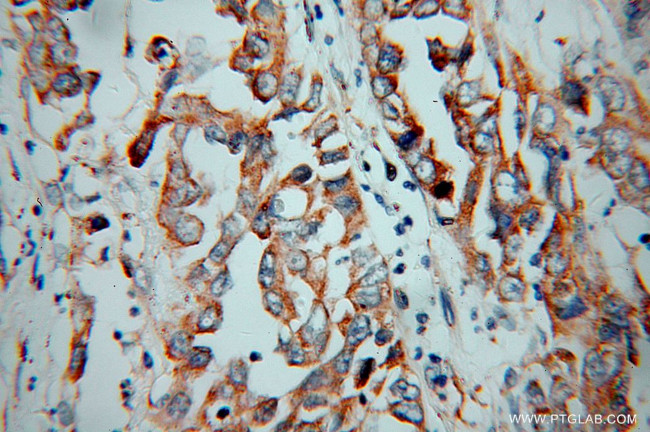
KChIP1 Antibody in Immunohistochemistry (Paraffin) (IHC (P))

Search
Proteintech
KChIP1 Polyclonal Antibody
{{$productOrderCtrl.translations['antibody.pdp.commerceCard.promotion.promotions']}}
{{$productOrderCtrl.translations['antibody.pdp.commerceCard.promotion.viewpromo']}}
{{$productOrderCtrl.translations['antibody.pdp.commerceCard.promotion.promocode']}}: {{promo.promoCode}} {{promo.promoTitle}} {{promo.promoDescription}}. {{$productOrderCtrl.translations['antibody.pdp.commerceCard.promotion.learnmore']}}
产品信息
14212-1-AP
种属反应
宿主/亚型
分类
类型
抗原
偶联物
形式
浓度
规格
纯化类型
保存液
内含物
保存条件
运输条件
产品详细信息
Immunogen sequence: MGAVMGTFS SLQTKQRRPS KDKIEDELEM TMVCHRPEGL EQLEAQTNFT KRELQVLYRG FKNECPSGVV NEDTFKQIYA QFFPHGDAST YAHYLFNAFD TTQTGSVKFE DFVTALSILL RGTVHEKLRW TFNLYDINKD GYINKEEMMD IVKAIYDMMG KYTYPVLKED TPRQHVDVFF QKMDKNKDGI VTLDEFLESC QEDDNIMRSL QLFQNVM (1-216 aa encoded by BC050375)
靶标信息
This gene encodes a member of the family of voltage-gated potassium (Kv) channel-interacting proteins (KCNIPs), which belong to the recoverin branch of the EF-hand superfamily. Members of the KCNIP family are small calcium binding proteins. They all have EF-hand-like domains, and differ from each other in the N-terminus. They are integral subunit components of native Kv4 channel complexes. They may regulate A-type currents, and hence neuronal excitability, in response to changes in intracellular calcium. Alternative splicing results in multiple transcript variant encoding different isoforms.
仅用于科研。不用于诊断过程。未经明确授权不得转售。
篇参考文献 (0)
生物信息学
蛋白别名: A-type potassium channel modulatory protein 1; A-type potassium channel modulatory protein KCNIP1; ABP; KChIP1; KCHIP2; KCNIp1; KCNIP1-Ia#II; KCNIP1-Ib; KCNIP1-Ib#II; KCNIP1-Ib+75inV; Kv channel interacting protein 1; Kv channel-interacting protein 1; neuronal calcium sensor-1 homolog; potassium channel interacting protein 1; Potassium channel-interacting protein 1; unnamed protein product; VABP protein; Vesicle APC-binding protein
基因别名: KCHIP1; KCNIP1; VABP
UniProt ID: (Human) Q9NZI2
Entrez Gene ID: (Human) 30820